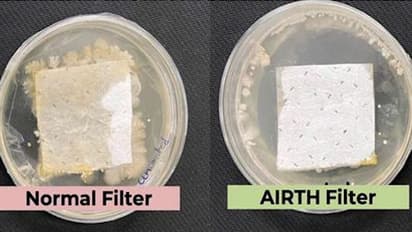
IISc researchers develop antimicrobial air filters that can mitigate air-borne infections; check details

A research team from Indian Institute of Science, Bengaluru (IISc) has newly developed an air filter that can deactivate the germs by 'self-cleaning' them out of the system using ingredients that are commonly found in green tea.
According to a report by the University of Chicago, impure air likely makes people's life shorter. This development comes in a bid to extend people's life by not losing 5-10 years of their lives due to air-borne contaminants that lead to respiratory diseases that adversely affects physical health as well as mental health.
Also read: Spalshdown! NASA's Orion capsule returns to Earth after 25-day lunar flight
A research team led by Prof Suryasarathi Bose and Prof Kaushik Chatterjee at Indian Institute of Science, Bengaluru (IISc), Bangalore, developed germ-destroying air filters that can inactivate germs using ingredients like polyphenols and polycationic polymers commonly found in green tea. These "green" ingredients rupture the microbes through site-specific binding.
The research was supported by special grants from Science and Engineering Research Board (SERB) during the challenging Covid-19 pandemic and SERB-Technology Translation Awards (SERB-TETRA) funds and a patent has been filed on this.
Also read: SpaceX's first private-funded Moon trip to include Indian actor Dev Joshi, K-pop star & others
Over continuous usage, the existing air filters become a breeding ground for captured germs. The growth of these germs clog the pores of the filter, reducing the life of the filters.
Resuspension of these germs can infect people in the vicinity. The antimicrobial air filters were tested at the NABL Accredited Laboratory and were found to deactivate SARS-CoV-2 (delta variant) with an efficiency of 99.24%.
This technology was transferred to AIRTH, a startup that is replacing the existing germ-growing air filters with germ-destroying air filters for commercialisation.
Also read: COVID was man-made virus, reveals former Wuhan lab scientist in a new book
As this innovation holds promise to develop antimicrobial filters that can prevent endemics caused by air-borne pathogens, a patent was granted in 2022. These novel antimicrobial filters in our ACs, central ducts and air purifiers can play a crucial role in our fight against air pollution and mitigate the spread of air-borne pathogens such as novel coronaviruses.